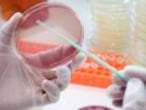

Resistência a antibióticos causa 33.000 mortes por ano na Europa
Impacto desse problema de saúde pública é semelhante ao da gripe, tuberculose e AIDS juntas


Mais de 33.000 europeus morrem a cada ano por infecções provocadas por bactérias que desenvolveram resistências a antibióticos. Esse impacto sobre a saúde da população já é semelhante ao somado pelas três principais doenças infecciosas: gripe, AIDS e tuberculose. Esta é uma das principais conclusões de uma ampla pesquisa do Centro Europeu para a Prevenção e o Controle de Doenças (ECDC, na sigla em inglês).
O estudo, o maior feito até hoje por essa instituição, destaca que em 39% dos casos as bactérias envolvidas já são imunes aos antibióticos ditos “de última linha”, como as colistinas e as carbapenemas. Isto, segundo o ECDC, desenha um cenário “muito preocupante, porque esses antibióticos são os últimos tratamentos disponíveis”. “Quando já não são mais eficazes, fica extremamente difícil, e em muitos casos impossível, tratar essas infecções”, explica o organismo. O estudo sustenta que as causas dessas resistências são o mau uso dos antibióticos e as insuficientes medidas de controle e prevenção das infecções.
A pesquisa se baseia em dados recolhidos ao longo de 2015 por uma grande rede de hospitais da União Europeia, além da Noruega e Islândia. Sobre essa informação, mediante estimativas matemáticas, os autores calculam que houve naquele ano 670.000 infecções causadas por bactérias multirresistentes, levando à morte de 33.110 pacientes. Essas estimativas levam em conta projeções sobre a população total dos países estudados e a mortalidade atribuída a cada uma das bactérias, entre muitas outras variáveis.
A novidade mais destacável do trabalho é que pela primeira vez um estudo desse tipo calcula o número de anos perdidos devido a doenças, deficiência ou morte prematura (DALYs, na sigla em inglês). Essa medida revela grandes diferenças entre os países pesquisados. Enquanto a média europeia chega a 170 anos por 100.000 habitantes, Itália e Grécia, líderes nessa lista, perdem 400 anos, enquanto Noruega, Holanda, Estônia e Islândia se situam abaixo dos 40.
“A conclusão de 170 DALYs por 100.000 habitantes é similar à soma do impacto sobre a população das três maiores doenças infecciosas, que são a gripe, a tuberculose e a AIDS”, constata o estudo.
Os autores destacam que quase duas de cada três infecções, 63,5% do total, foram “adquiridas no sistema sanitário”, principalmente hospitais, o que oferece uma “ampla margem de melhora” mediante a aplicação de medidas de prevenção e controle nos centros sanitários.
As principais bactérias envolvidas são velhas conhecidas dos profissionais sanitários, como a Acinetobacter spp., os Enterococcus faecalis e faecium, a Klebsiella pneumoniae, a Staphylococcus aureus (MRSA) e a Streptococcus pneumoniae. Trata-se de agentes patogênicos muito comuns, inicialmente sensíveis a todos os antibióticos, mas que nas últimas décadas foram desenvolvendo imunidade frente a vários tipos de medicamentos.
O trabalho foi feito por especialistas do ECDC em colaboração com dezenas de especialistas europeus, e foi publicado na revista de referência The Lancet Infectious Disease. Os autores admitem limitações em seu trabalho, dada a complexidade das estimativas matemática realizadas, mas defendem entre seus trunfos “a alta qualidade das fontes de dados”, em referência à coleta empreendida pela Rede Europeia de Vigilância da Resistência aos Antibióticos (EARS-Net, na sigla em inglês). Os especialistas também defendem “a revisão sistemática dos últimos estudos publicados para obter as melhores estimativas sobre a mortalidade atribuível às bactérias multirresistentes e suas complicações”.
O objetivo do trabalho é, segundo o ECDC, oferecer às autoridades europeias as informações mais atualizadas para enfrentar um problema que “exige uma estreita coordenação entre todos os países estudados e em nível global”. Diante das notáveis diferenças observadas entre os países, entretanto, o ECDC propõe “reduzi-las mediante medidas de prevenção e controle adequadas”, assim como “uma gestão precisa dos antibióticos”. “Tudo isso”, conclui o trabalho, “deve ser um objetivo prioritário para todos os países”.
Médico: "os pacientes me pedem"
A preocupação pelo mau uso dos antibióticos é global. Se o Centro Europeu para a Prevenção e o Controle de Doenças alerta para o problema na Europa, um trabalho apresentado no recente congresso da Sociedade Espanhola de Médicos de Atendimento Primário (Semergen), realizado em Palma de Mallorca, alerta para a margem de melhora nos centros de saúde.
O estudo, que reúne as respostas mais frequentes em uma pesquisa anônima com 120 médicos na região de Terrassa (na Grande Barcelona), destaca que a oitava mais repetida é que “se um paciente acreditar que precisa de um antibiótico, o conseguirá sem receita”. Alguns consideram que “prescrever um antibiótico não influirá na aparição de resistências”. E, embora minoritários, os profissionais médicos admitem: “Às vezes, prescrevo antibióticos porque os pacientes me pedem”; também “por falta de tempo para explicações”; e inclusive para que “continuem confiando em mim”.
O trabalho conclui que “embora os médicos estejam conscientes do problema, existe uma margem de melhora que justifica um Programa de Otimização do Uso de Antibióticos”.

Tu suscripción se está usando en otro dispositivo
¿Quieres añadir otro usuario a tu suscripción?
Si continúas leyendo en este dispositivo, no se podrá leer en el otro.
FlechaTu suscripción se está usando en otro dispositivo y solo puedes acceder a EL PAÍS desde un dispositivo a la vez.
Si quieres compartir tu cuenta, cambia tu suscripción a la modalidad Premium, así podrás añadir otro usuario. Cada uno accederá con su propia cuenta de email, lo que os permitirá personalizar vuestra experiencia en EL PAÍS.
¿Tienes una suscripción de empresa? Accede aquí para contratar más cuentas.
En el caso de no saber quién está usando tu cuenta, te recomendamos cambiar tu contraseña aquí.
Si decides continuar compartiendo tu cuenta, este mensaje se mostrará en tu dispositivo y en el de la otra persona que está usando tu cuenta de forma indefinida, afectando a tu experiencia de lectura. Puedes consultar aquí los términos y condiciones de la suscripción digital.